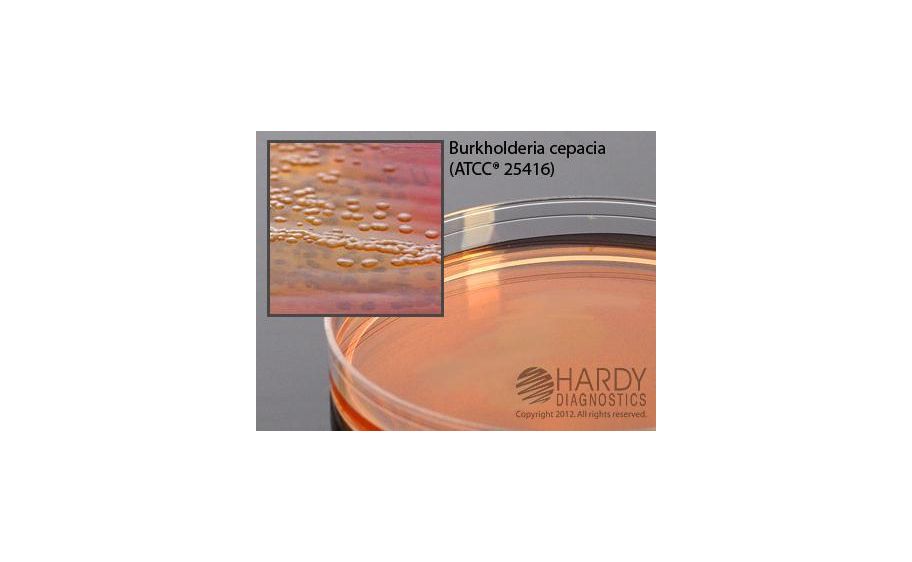
main product photo

Need Help?
800-229-7252

BCSA FOR B. CEPACIA
1
/
PK
Lead Time
12 Day(s)
SKU
VWR89423-720-PK
MFRPN
G09
BCSA FOR B. CEPACIA
Burkholderia cepacia Selective Agar For the selective isolation and differentiation of Burkholderia (Pseudomonas) cepacia from sputum samples from cystic fibrosis patients and other clinical specimens.
| Manufacturer | Hardy Diagnostics |
|---|---|
| MFRPN | G09 |
| Lead Time | 12 Day(s) |
| UNSPSC Code | 12000000 |
Write Your Own Review